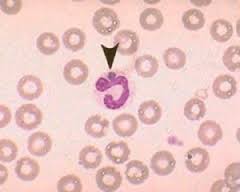

Ερλιχίωση
Η ερλιχίωση του σκύλου, είναι μια βακτηριακή νόσος, η οποία προκαλείται από τους υποχρεωτικά ενδοκυτταρικούς κόκκους των βακτηρίων, που ανήκουν στο γένος Ehrlichia. Το πιο συχνό είδος του βακτηρίου, που ευθύνεται για την νόσο στην Ελλάδα , είναι η Ehrlichia canis. Η νόσος προσβάλει κατά κύριο λόγω τους σκύλους. Το βακτήριο μεταδίδεται μέσω των μολυσμένων κροτώνων –τσιμπουριών (του γένους Rhipicephalus sanguineous, το οποίο υπάρχει σε αφθονία στην Ελλάδα) και δεν υπάρχει περίπτωση άμεσης μετάδοσης του, τόσο από σκύλο σε σκύλο, όσο και από σκύλο σε άνθρωπο. Η E.canis, παρασιτεί συχνότερα στα μονοκύτταρα του αίματος και τα μακροφάγα των λεμφογαγγλίων, του σπλήνα, του ήπατος και του μυελού των οστών, προκαλώντας έντονη υπερπλασία των οργάνων αυτών, καθώς και σοβαρότατες αιματολογικές διαταραχές. Ακόμη, το βακτήριο καταστρέφει και τα αιμοπετάλια, δυσχαιραίνοντας κατά πολύ την πήξη του αίματος.
Συμπτώματα: Δυστυχώς, τα συμπτώματα της νόσου αργούν να εμφανιστούν, καθώς παρουσιάζονται συνήθως ένα μήνα μετά το τσίμπημα του μολυσμένου τσιμπουριού. 

Οι σκύλοι, εμφανίζουν συχνότερα, ανορεξία ή/και κατάπτωση, που οφείλονται σε υψηλό πυρετό (40 – 41 οC), αιμορραγική διάθεση (ρινική αιμορραγία, αίμα στα ούρα ή στα κόπρανα, ύφαιμα - αιμορραγία του πρόσθιου θαλάμου του ματιού, κ.α.), καθώς και ωχρότητα των βλεννογόνων. Αν και η νόσος μπορεί να προσβάλλει όλες τις φυλές των σκύλων, κάποιες, όπως τα German shepherd και τα Doberman, φαίνεται να είναι πιο ευπαθή και να παρουσιάζουν βαρύτερη κλινική εικόνα.
Διάγνωση: Η τελική διάγνωση της νόσου, μπορεί να γίνει μόνο με ειδικό ορολογικό test, παρόμοιο με αυτό της λεϊσμάνιας.
Θεραπεία: Η θεραπεία της νόσου, στηρίζεται στην ειδική αντιβακτηριακή αγωγή για σχετικά μεγάλο χρονικό διάστημα, καθώς και στην εξάλειψη, τυχών επιμολύνσεων. Η θεραπεία, είναι στις περισσότερες των περιπτώσεων αποτελεσματική, αν και για την θετική της έκβαση παίζει πολύ μεγάλο ρόλο το στάδιο της νόσου, κατά το οποίο θα προσκομιστεί το ζώο στο κτηνιατρείο.
Πρόληψη: Η πρόληψη της νόσου, είναι ιδιαίτερα σημαντική και συνίσταται, σχεδόν αποκλειστικά στον «ευλαβικό» αποπαρασιτισμό των ζώων μας, από τα εξωπαράσιτα. 
Κτηνίατρος Α.Π.Θ.


